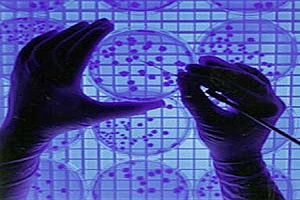
خبر خوش برای بیماران ژنتیکی

مازندرانه گزارش می دهد ؛
دانشگاه علوم پزشکی مازندران حائز رتبه های برتر در نخستین دوره جشنواره مدیریت دانش منطقه یک آمایشی کشور

خبر خوش شهردار رینه به مردم؛
رایزنی ها و پیگیری ها برای فعالیت درمانگاه شبانه روزی و استقرار اورژانس ۱۱۵ در رینه لاریجان آغاز شد

رییس شبکه بهداشت آمل تشریح کرد؛
آخرین وضعیت پروژه های بهداشت و درمان شهرستان آمل
 بهره مندی از انرژی هسته ای برای مراقبت از سلامت مردم
بهره مندی از انرژی هسته ای برای مراقبت از سلامت مردم
دکتر سیدحسن هاشمی در مراسم امضای تفاهم نامه ی احداث و تامین منابع مالی مرکز آموزشی، پژوهشی، تشخیصی و درمانی سرطان، گفت: از اینکه سازمان انرژی اتمی در حوزه اجتماعی به ویژه در حوزه سلامت، گام های سودمندی را برمی دارد، تشکر می کنم. وی با بیان اینکه هرسال شاهد به نتیجه رسیدن پروژه هایی […]...
 ضرورت تامین مواد اولیه تجهیزات پزشکی در تحریم ها
ضرورت تامین مواد اولیه تجهیزات پزشکی در تحریم ها
دکتر رضا مسائلی با بیان اینکه وزارت بهداشت تمام تلاشش را خواهد کرد تا نواقص موجود در حوزه تجهیزات پزشکی برطرف شود، اظهار داشت: با توجه به مشکلات موجود و شرایط فعلی کشور باید تلاش کنیم تا به بهترین شکل بر تحریم ها غلبه کنیم. وی تصریح کرد: علاوه بر وجود مشکلاتی مانند قیمت گذاری […]...
 بیماری های عفونی دوران بارداری برای سلامت مادر و جنین خطرناک است
بیماری های عفونی دوران بارداری برای سلامت مادر و جنین خطرناک است
دکتر فرهاد یغمایی عضو تیم تخصصی مرکز درمان ناباروری ابن سینا، ضمن اشاره به فرایند بارداری، اظهارداشت: تولد یک نوزاد سالم مهم ترین هدف بارداری است اما متاسفانه در طول دوران بارداری سلامت مادر و جنین توسط عوامل مختلف عفونی مورد تهدید قرار میگیرد که میتوانند عوارض حاد و زودرس، و یا دیررس را ایجاد [&h...
 خطرات انجام بوتاکس در آرایشگاه ها/توصیه به مردم
خطرات انجام بوتاکس در آرایشگاه ها/توصیه به مردم
دکتر سید نجات حسینی دانشیار دانشگاه علوم پزشکی زنجان، اظهارداشت: جراحان پلاستیک و زیبایی در بخشهای عمده جراحیهای بازسازی، جراحی مشکلات مادرزادی همچون شکاف کام و لب، جراحی حوادث، سوختگی، تصادفات و بازسازی جای برداشت تومور فعالیت دارند. وی افزود: بخش عمده دیگر فعالیت جراحان پلاستیک موضوع زیبایی بوده...
 مردم سالانه ۵ تریلیون پلاستیک استفاده می کنند/ «غلبه بر آلودگی پلاستیک» شعار جهانی امسال
مردم سالانه ۵ تریلیون پلاستیک استفاده می کنند/ «غلبه بر آلودگی پلاستیک» شعار جهانی امسال
سازمان ملل متحد (UN)، پانزدهم خرداد برابر با پنجم ژوئن را، «روز جهانی محیط زیست» نامگذاری کرده است. بخش محیطزیست سازمان ملل متحد(UNEP)، دستورالعملهای مربوط به محیط زیست را تنظیم میکند و پیادهسازی منسجم ابعاد محیط زیستی توسعهی پایدار در سیستم این سازمان را، برعهده دارد. این بخش همچنین در نقش ...
 فرهنگ توجه به سلامت را باید در جامعه نهادینه کنیم
فرهنگ توجه به سلامت را باید در جامعه نهادینه کنیم
محمد اسلامی، استاندار مازندران در نشست با اعضاء سازمان نظام پزشکی استان با اشاره به این که سلامت جامعه از تکالیف بنیادی و اولیه حاکمیت است، تصریح کرد: نیاز داریم فرهنگ توجه به سلامت را در جامعه نهادینه کنیم به نحوی که پیشگیری مقدم بر درمان به معنای واقعی کلمه محقق شود. رییس کارگروه سلامت […]...
 چه کنیم تا بعد از ماه رمضان چاق نشویم؟
چه کنیم تا بعد از ماه رمضان چاق نشویم؟
سمانه رمضانی گیوی متخصص طب سنتی در گفت وگویی بیان کرد: در خصوصجلوگیری از چاقی در ماه مبارک رمضان، اظهار کرد: افراد در ماه رمضان باید به نوع خوراک خود حتما توجه کنند؛ این ماه بیشتر در سفره ها زولبیا و بامیه وجود دارد که بسیار افراد را تشویق به مصرف می کند، اما باید […]...
 چگونه فشار خون خود را تنظیم کنیم؟
چگونه فشار خون خود را تنظیم کنیم؟
روز ۱۷ ماه می هرسال به نام روز جهانی فشارخون (World Hypertension Day) نامیده میشود و هدف از مشخص کردن این روز، افزایش آگاهی، پیشگیری، تشخیص و کنترل فشارخون در افراد در ردههای سنی مختلف است. شعارامسال روزجهانی فشارخون، نمره هایت را بدان (Know your numbers)، منظور آگاهی از بیشینه و کمینه فشارخون اس...
 وقتی قوانین فیزیک در این سحابی فضایی نقض میشود + تصاویر
وقتی قوانین فیزیک در این سحابی فضایی نقض میشود + تصاویر
کارشناسان به تازگی موفق به شناسایی نور لیزر ساطع شده از سحابی مورچه (the Ant Nebula) با استفاده از تلسکوپ فضایی هابل شده اند. تیمی ازدانشمندان درحال بررسی پدیده نادر بازتابش نور لیزر از قلب سحابی سیارهای (Menzel ۳) هستند که به نام سحابی مورچه شناخته میشود. سحابی Menzel ۳، در فاصله ۸ هزارسال نوری ا...
 تعیین تکلیف وضعیت پایه اول متوسطه سمپاد و نمونه دولتی تا چند روز آینده/ برای رسیدگی به پرونده صندوق ذخیره منتظر قوه قضاییه هستیم
تعیین تکلیف وضعیت پایه اول متوسطه سمپاد و نمونه دولتی تا چند روز آینده/ برای رسیدگی به پرونده صندوق ذخیره منتظر قوه قضاییه هستیم
سید محمد بطحایی وزیر آموزش و پرورش در حاشیه انتخابات صندوق دخیره فرهنگیان و در جمع خبرنگاران درباره پاداش پایان خدمت معلمان بیان کرد: براساس پیش بینی مجلس این پاداش در قالب تنخواه پرداخت خواهد شد. وزیر آموزش و پرورش درباره تغییرات در آزمون تیزهوشان گفت: نوع آزمون تفاوت خواهد کرد و به جهت رعایت اصول ...
 تزریق هزار میلیارد تومان به بیمه سلامت طی ۳ روز آینده/ سالیانه ۹۰۰ میلیارد تومان برای بیماران خاص هزینه میشود
تزریق هزار میلیارد تومان به بیمه سلامت طی ۳ روز آینده/ سالیانه ۹۰۰ میلیارد تومان برای بیماران خاص هزینه میشود
طاهر موهبتی مدیر عامل بیمه سلامت صبح امروز در نشست خبری که برگزار شد، اظهار کرد: امروز حدود ۶۴ هزار نفر در کشور با عنوان بیمار خاصدر سازمان بیمه سلامت تحت پوشش و حمایت قرار دارند به طوریکه سالیانه ۹۰۰ میلیارد تومان برای این افراد در کشور هزینه میشود که در این بین بیشترین هزینه برای بیماران دیالیزی ...
 ثبت نام آزمون استخدامی دستگاههای اجرایی از ساعت ۱۸ آغاز میشود
ثبت نام آزمون استخدامی دستگاههای اجرایی از ساعت ۱۸ آغاز میشود
حسین توکلی مشاور عالی سازمان سنجش در گفتوگویی اظهار کرد: ثبت نام پنجمین آزمون مشترک فراگیر دستگاههای اجرایی کشور برای جذب ۱۸ هزار و ۲۰۷ نفر در ۹ دستگاه اجرایی وزارت آموزش و پرورش، سازمان دامپزشکی کشور ، سازمان شیلات کشور، وزارت راه و شهرسازی، سازمان حفاظت محیط زیست، وزارت امور اقتصادی و دارایی، سا...
خبر خوش برای بیماران ژنتیکی
خبر خوش برای بیماران ژنتیکی
رضا ملکزاده معاون تحقیقات و فناوری وزارت بهداشت در حاشیه سومین کنگره بینالمللی و پانزدهمین کنگره ملی ژنتیک ایران که صبح امروز در سالن اجلاس سران برگزار شد، در جمع خبرنگاران درباره علم ژنتیک، اظهار کرد: خوشبختانه در علم ژنتیک در ۳ تا ۴ سال اخیر اتفاقات مهمی رخ داده است و ما میتوانیم به کمک تکنیکه...
 وضعیت برنامه امتحانات پایان ترم دانشگاهها در ماه رمضان
وضعیت برنامه امتحانات پایان ترم دانشگاهها در ماه رمضان
به تدریج با اتمام نیمسال دوم تحصیلی دانشگاه ها حال و هوای دانشجوها تغییر کرده و برای امتحانات آماده می شوند البته چند سالی است تقارن ماه مبارک رمضان و ایام امتحانات شرایط ویژه ای را برای محصلان ایجاد کرده است، بنابراین شرایط در تقویم آموزشی دانشگاه ها تغییراتی ایجاد شده است که برای اطلاع از نحوه...
 گزارشی از بازار سیاه سلامت؛ جولان داروهای مرگ آور و پزشکان قلابی در هندوستان کوچک ایران/ وقتی جان مردم وسیله ای برای دلالی می شود
گزارشی از بازار سیاه سلامت؛ جولان داروهای مرگ آور و پزشکان قلابی در هندوستان کوچک ایران/ وقتی جان مردم وسیله ای برای دلالی می شود
سال هاست که سیستان و بلوچستان به دلیلی هم مرزی با افغانستان و پاکستان شاهد ورود کالاهای قاچاق است که در این بین بازار داغ داروهای قاچاق و تقلبی داغ تر است. علی ای حال شهرستان سرباز یکی از شهرستان هایی است که بیشتر مورد توجه قاچاقچیان دارو قرار گرفته است؛ این قاچاقچیان با سوء […]...
 احساس رضایتی که مردم از طرح تحول سلامت می کردند باید به آنها بازگردد
احساس رضایتی که مردم از طرح تحول سلامت می کردند باید به آنها بازگردد
همایون هاشمی عضو کمیسیون بهداشت مجلس شورای اسلامی در خصوص آخرین وضعیت اجرای طرح تحول سلامت در کشور اظهار داشت: این طرح یک حرکت فرابخشی بوده که باید سایر بخش ها نیز در اجرای این طرح عوامل آن را یاری کنند. وی با بیان اینکه یکی از چالش های این طرح موضوع بیمه های بیماران […]...
 اعتراض پزشکان به تعرفه ۵ درصدی شورای عالی سلامت + صوت
اعتراض پزشکان به تعرفه ۵ درصدی شورای عالی سلامت + صوت
برنامه پیک بامدادی رادیو ایران به موضوع اعتراض پزشکان به میزان افزایش نرخ تعرفه خدمات پزشکی پرداخته است. پس از کش و قوسهای بسیار، بالاخره روز گذشته میزان افزایش نرخ تعرفه خدمات پزشکی دولتی و خصوصی، ۵ درصد اعلام شد. بخش خصوصی به این افزایش ۵ درصدی اعتراض کرده است اما بعضی افراد میگویند تعرفه [&hell...
 بازیگر سریال لیسانسهها در انتظار جراحی +عکس
بازیگر سریال لیسانسهها در انتظار جراحی +عکس
امیر کاظمی به تازگی تصویری از خود روی تخت بیمارستان منتشر و با بیان طنز عنوان کرد که آماده رفتن به اتاق عمل است. او در پست خود نوشت: “پیش به سوى اولین تجربه بیهوشى و عمل جراحى و این داستانها! پ. ن.: خدمت دانشمندان عزیز عرض کنم که روى تابلو نوشته پرستار: خانم حیدرى!خدمت یکسرى از محققین [&helli...
 زنان تغذیه مناسب در ۳ ماه اول بارداری را جدی بگیرند
زنان تغذیه مناسب در ۳ ماه اول بارداری را جدی بگیرند
علیرضا یاراحمدی، متخصص مغز و اعصاب در مورد راهکار ارتقای سلامت مغزی جنین اظهارداشت: رشد مغزی و سیستم اعصاب در سه ماهه اول بارداری شکل میگیرد، دورانی که اگر به هرعلتی تغدیه مادر مناسب نباشد و مواد مغذی مورد نیار به وی نرسد، این رشد با مشکلاتی مواجه میشود. این متخصص مغز و اعصاب و […]...
 تعلل بیمههای تجاری در پرداخت سهم وزارت بهداشت از حق بیمه شخص ثالث
تعلل بیمههای تجاری در پرداخت سهم وزارت بهداشت از حق بیمه شخص ثالث
حیدر علی عابدی درباره هشدار وزارت بهداشت به بیمهها مبنی برضرورت پرداخت سهم این وزارتخانه از اعتباراتی که مردم بابت درمان در تصادفها پرداخت میکنند، گفت: مجلس تخلف بیمههای تجاری را پیگیری میکند. نماینده مردم اصفهان درمجلس شورای اسلامی، با اشاره به اینکه بر اساس قانون برنامه چهارم توسعه، وزارت به...


